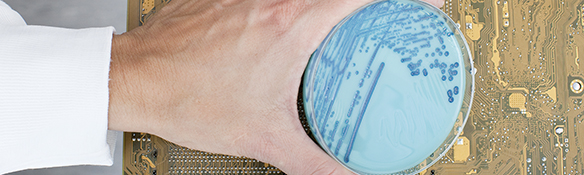

Synthetic biology is a technoscientific development whereby technical design principles are applied at a molecular biology level. These techniques are now developing very fast, are being widely applied and are expected to have a huge economic impact. With its knowledge of health and the environment, RIVM is also playing its part in the responsible development of synthetic biology.
All over the world, scientists and industry are working on the development and application of synthetic biology. Nationally and internationally, advisory bodies and governments are addressing this subject.
Knowledge of the mechanisms of biological systems at genetic and molecular level has increased greatly over recent years. In addition, techniques and tools designed to enable focused development and building at the molecular and genetic level have become available.
Impact
The development of synthetic biology has numerous consequences for people and society. It may contribute to the reduction of CO2 emissions, to making the economy greener (bio-based economy), and to public health (nutrition, medicines, antibiotics and gene therapy).
Synthetic biology provides opportunities for new production routes for chemicals that can be used to provide energy, medicines, artificial odours and flavourings, and as raw materials for the chemical industry.
Work is also being carried out on the development of new types of antibiotics. Yet other developments are focused on biosensors that can be used to detect decay in foodstuffs or specific types of environmental pollution.
However, as these new techniques become available questions are also being generated. Not only are there societal and ethical questions, but also questions concerning risks to people and the environment and about safety.
Role of RIVM
RIVM is playing its part in the responsible development of synthetic biology. We are doing this by looking at the significance of these developments in relation to health, the environment, sustainability and safety. RIVM is developing its own knowledge and expertise in the field of synthetic biology by means of scientific research.
RIVM is also assimilating existing knowledge. On behalf of central government we are setting up a Knowledge Information Point on synthetic biology in which various interested parties will participate. RIVM is producing a newsletter which contains important developments in the field of synthetic biology.
Moreover, RIVM is strengthening collaboration with important knowledge centres such as the Rathenau Institute.
Policy and societal developments
RIVM is supporting policy-makers by actively contributing to the expansion and transfer of knowledge and by participating in and supporting a number of international advisory groups (i.e. Convention on Biodiversity, OECD, (European Union) Commission on newly developing risks).
RIVM wants to both initiate policy-wide discussion on the development of synthetic biology (iGEM) and to follow this up. We are also actively monitoring the type of contributions being made to societal discussions. We are doing this by means of knowledge development and research.